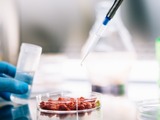

Latest Comment And Analysis
Sponsored Feature: Building confidence in every byte: strengthening food safety through advanced laboratory innovation
Added: 23 Mar 2026
Discover how laboratory digitalisation, supported by the use of a LIMS, is contributing to changes …

Sustainably feeding the world with genomics-driven agriculture
Added: 5 Mar 2023
As cell meat manufacture develops in the lab, science is increasingly impacting arable farming in t…

From petri dish to dinner plate
Added: 27 Feb 2023
Lab grown meat is developing into a multibillion pound industry but scaling up has challenges, expl…

How food microbiology contract labs can drive sustainable impact
Added: 19 Jun 2022
Safe and trusted food is essential for the food industry to prosper — especially in today’s landsca…

Making an impact in remote laboratory research
Added: 16 Feb 2022
During Lab Innovations last November, Anna Cooper and Raymond Wong were delighted to pick up the ‘M…

How food and drink labs have adapted since COVID-19
Added: 27 Oct 2021
With the start of the COVID-19 pandemic, we saw the mass stock-piling of food products like chicken…

Wheat field trial heralds UK acceptance of gene edited crops
Added: 13 Oct 2021
Post Brexit, the UK is free to make its own decisions around genetic editing of food crops based on…

Singing the praises of odd numbers
Added: 23 Sep 2019
Annoy peer reviewers and create an inclusive numerical policy? It’s a win win for Dr Matthew Partri…

The good, the bad and the brexit
Added: 16 Sep 2019
The new Government has been in place for only a few weeks now and in that time, we’ve already had a…

Are you ready for show time?
Added: 9 Sep 2019
Once again we are delighted to have partnered with the Lab Innovations show – and we want you to be…

Ghost of science future
Added: 2 Sep 2019
Well, here we are. Four months from the completion of the second decade in the third millennium.

You are never too successful for lunch
Added: 12 Aug 2019
Everyone knows that the fulcrum around which a successful lab swings is, of course, lunch. But what…

Advancing a technical career
Added: 12 Aug 2019
Is your team motivated, professional, adaptable, connected, and competent?

Brexit: No-deal is a bad deal for UK science
Added: 9 Aug 2019
In a video livestreamed from his desk at Downing Street on Thursday, Prime Minister Boris Johnson a…

Reproducibility crisis
Added: 23 Jul 2019
Inadequate reporting, variability in reagents and the pressure to publish all contribute to the rep…

Glorious celebration of imposters
Added: 17 Jun 2019
Ever wondered, despite all your scientific expertise, if you’ll be uncovered as a fraud? Don’t worr…

Moral morsels
Evoluted New Media | Added: 22 Apr 2019
It is a troubling business. The simple act of lifting a morsel to your mouth is now fraught with di…

